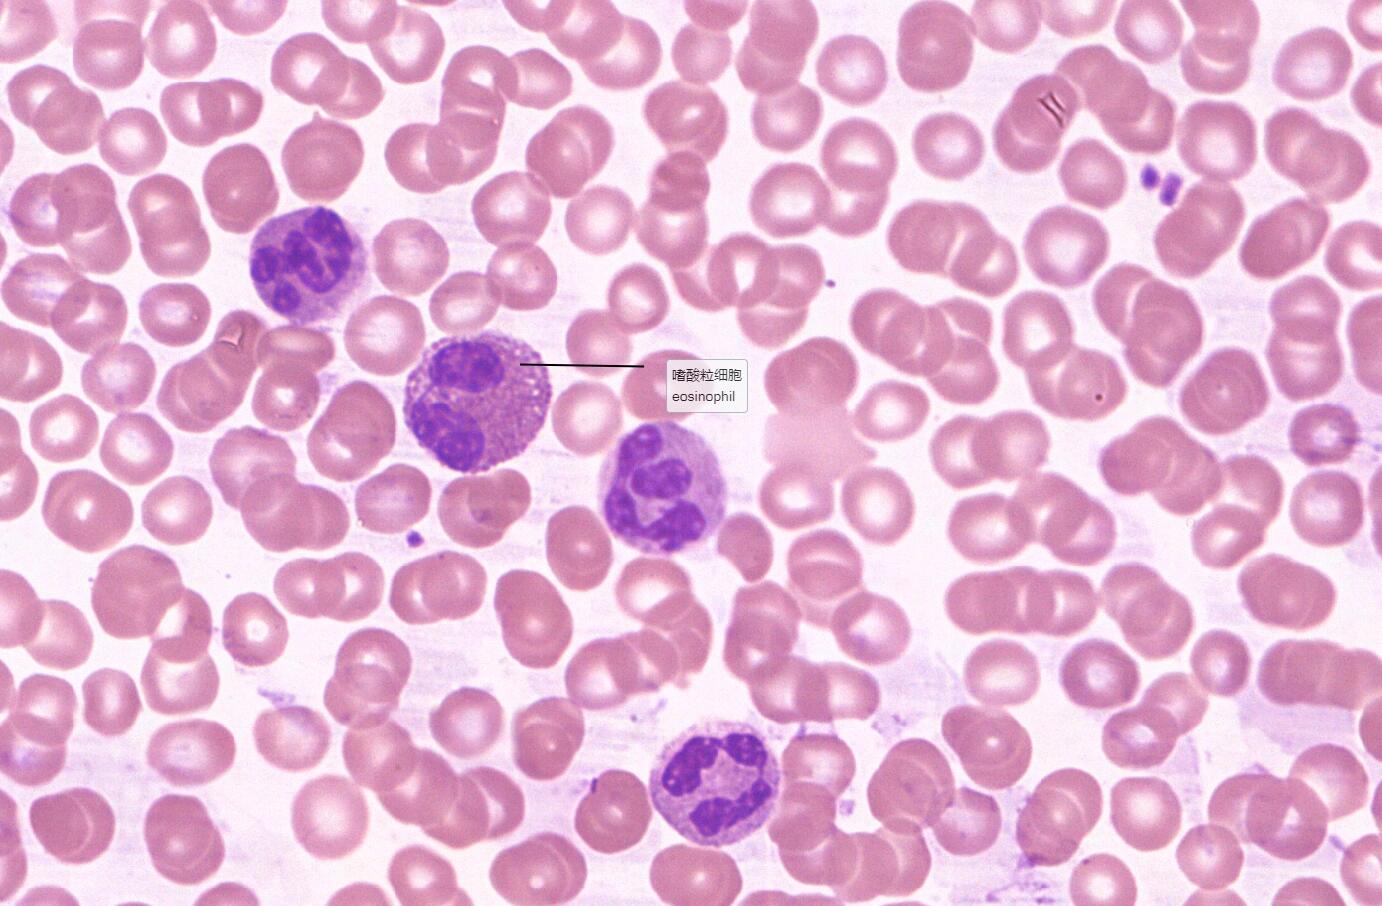
5 血液:白细胞5分类 名称:血涂片 染色:瑞氏染色(10×) 来源:人 描述

白细胞形态图手绘

白细胞绘图
图片尺寸1242x1656
实验报告/白细胞形态检查
图片尺寸1920x2560
外周血正常形态白细胞手绘图
图片尺寸960x1280
【检验】形态学图谱②Ⅱ白细胞形态学图谱
图片尺寸1013x1280
白细胞守卫我们身体健康的战士!#一起学画 - 抖音
图片尺寸1920x1440
组织学与胚胎学——卵泡红蓝铅笔画图
图片尺寸1920x2560
血涂片观察(红细胞and白细胞) 好不容易没写错字
图片尺寸1707x1280
这白细胞帅炸了!#手绘 #临摹 #工作细胞 #黑白画 - 抖音
图片尺寸1440x1920
各阶段的细胞图|红蓝铅笔手绘
图片尺寸1280x1280
91白细胞手绘图片大揭秘96
图片尺寸1080x1410
学生的手绘细胞结构图.#手绘 #细胞结构绘画 #生物 - 抖音
图片尺寸1440x1920
91白细胞手绘图片大揭秘96
图片尺寸1080x1410
p>白细胞直方图 br>正常白细胞直方图异常曲线形态改变主要位置 /p>
图片尺寸1920x2428
外周血异常白细胞形态
图片尺寸1200x600
血涂片观察(红细胞and白细胞) 好不容易没写错字
图片尺寸1022x1280
5 血液:白细胞5分类 名称:血涂片 染色:瑞氏染色(10×) 来源:人 描述
图片尺寸1382x906组胚实验报告画图
图片尺寸1080x920
教材疑点通你不知道的白细胞_碱性_颗粒_组织
图片尺寸1080x1022
段师形态教学系列(第59期)_检验_课堂_白细胞
图片尺寸785x800
前列腺液镜检×1000 形态特点:正常前列腺液中可以见到较丰富的圆形
图片尺寸1818x1818
猜你喜欢:白细胞战斗的卡通图片白细胞红蓝铅笔手绘图五种白细胞红蓝铅笔图五种白细胞形态图分辨白细胞简图五种白细胞的手绘图白细胞图片手绘图白细胞形态图五种白细胞形态图放线菌形态图手绘图白细胞工作细胞图片工作细胞白细胞污图工作细胞白细胞腐图白细胞图片简笔画大肠杆菌形态图手绘白细胞结构简图酵母菌形态图手绘白细胞形态花粉形态图手绘白细胞图片卡通白细胞图片工作细胞白细胞女工作细胞白细胞白细胞图片显微镜白细胞图片吞噬细菌形态图显微镜下白细胞图片白细胞吞噬细菌手绘图白细胞全身保佑排位连胜头像楹联展获奖书法作品悦刻电子烟杆拆解图动漫封面素材校园纳克萨玛斯防战天赋呆妹小袁巴西龟图片小时候最帅的sans声乐老师王鑫简介曜变天目盏图片梁孝王陵河东实验小学